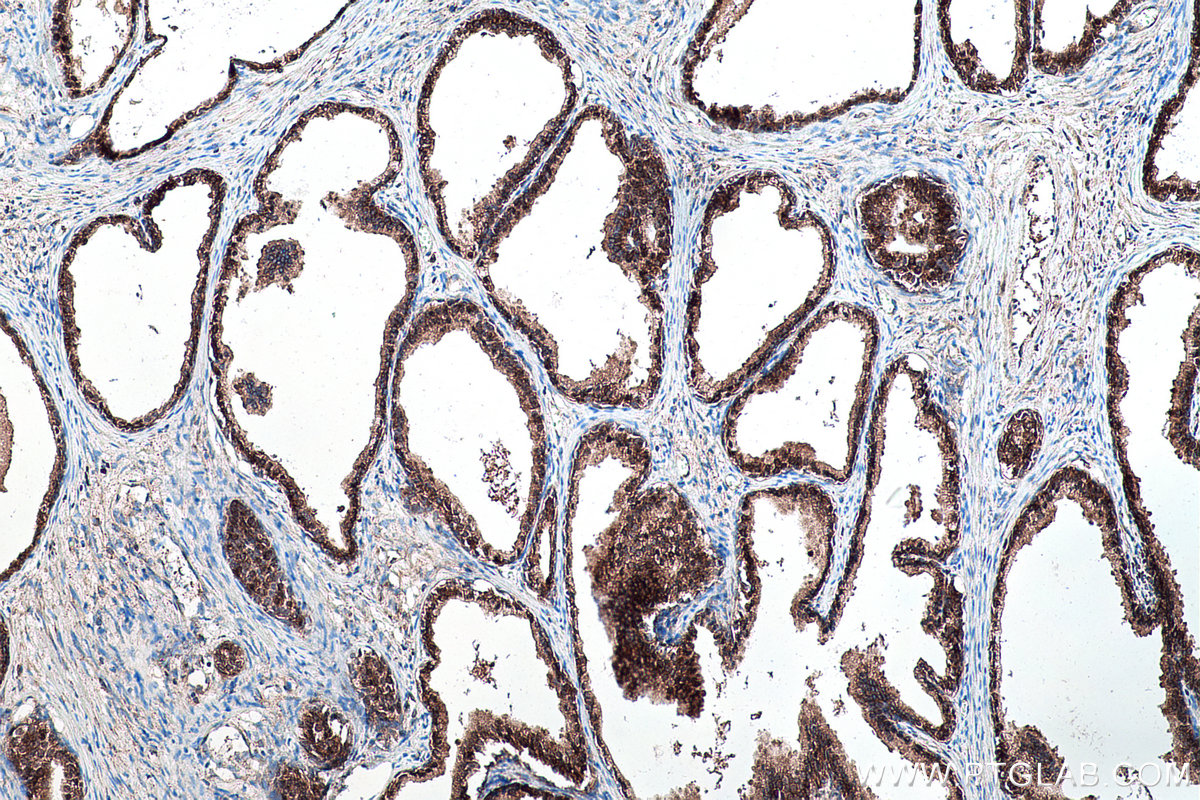

IHCeasy® YBX1 Ready-To-Use IHC Kit
YBX1 Ready-to-use reagent kit for IHC.
Reactivity
Human, Mouse, Rat
Sample Type
FFPE tissue
Cat no : KHC0176
Synonyms
BP 8, CBF A, CSDA2, CSDB, DBPB, DNA binding protein B, EFI A, Enhancer factor I subunit A, MDR NF1, NSEP 1, NSEP1, Y box binding protein 1, Y box transcription factor, YB 1, YB1, YBX1
Validation Data Gallery
Product Information
KHC0176 is a ready-to-use IHC kit for staining of YBX1. The kit provides all reagents, from antigen retrieval to cover slip mounting, that require little to no diluting or handling prior to use. Simply apply the reagents to your sample slide according to the protocol and you're steps away from obtaining high-quality IHC data.
| Product name | IHCeasy YBX1 Ready-To-Use IHC Kit |
| Sample type | FFPE tissue |
| Assay type | Immunohistochemistry |
| Primary antibody type | Rabbit Polyclonal |
| Secondary antibody type | Polymer-HRP-Goat anti-Rabbit |
| Reactivity | Human, Mouse, Rat |
Kit components
| Component | Size | Concentration |
|---|---|---|
| Antigen Retrieval Buffer | 100 mL | 50× |
| Washing Buffer | 100 mL ×2 | 20× |
| Blocking Buffer | 5 mL | RTU |
| Primary Antibody | 5 mL | RTU |
| Secondary Antibody | 5 mL | RTU |
| Chromogen Component A | 0.2 mL | RTU |
| Chromogen Component B | 4 mL | RTU |
| Signal Enhancer | 5 mL | RTU |
| Counter Staining Reagent | 5 mL | RTU |
| Mounting Media | 5 mL | RTU |
| Datasheet | 1 Copy | |
| Manual | 1 Copy |
Background Information
Y box binding protein 1(YBX1) is one of cis-acting elements which has a role in regulation of the expression of HLA class II genes. YBX1 is great of importance in regulation of PTP1B expression. It can bind to splice sites mediate pre-mRNA alternative splicing regulation. Also it involves in the regulation of translation by modulation of the interaction between the mRNA and eukaryotic initiation factors. Its transcriptional activity on the multidrug resistance gene MDR1 is enhanced in presence of the APEX1 acetylated form at 'Lys-6' and 'Lys-7'. The secreted form acts as an extracellular mitogen and stimulates cell migration and proliferation.
Properties
| Storage Instructions | All the reagents are stored at 2-8°C. The kit is stable for 6 months from the date of receipt. |
| Synonyms | BP 8, CBF A, CSDA2, CSDB, DBPB, DNA binding protein B, EFI A, Enhancer factor I subunit A, MDR NF1, NSEP 1, NSEP1, Y box binding protein 1, Y box transcription factor, YB 1, YB1, YBX1 |